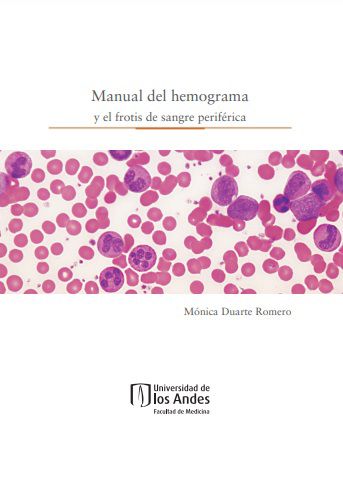

Descripción
El hemograma y el frotis de sangre periférica son los exámenes básicos de la evaluación biológica de todo paciente, en cualquier área clínica médica o quirúrgica. El análisis detallado y la adecuada interpretación de cada uno de los parámetros hematológicos, proporcionan información para el diagnóstico preciso y tratamiento adecuado de gran variedad de patologías. También son valores de utilidad en la evolución de las enfermedades y en el seguimiento de la respuesta al tratamiento. Este manual pretende recordar a estudiantes y médicos de todas las especialidades, los valores normales de los parámetros hematológicos fundamentales y las características y cualidades de las células normales y anormales, mediante imágenes tomadas de las muestras de sangre o de la médula ósea de algunos pacientes, y su descripción morfológica detallada. El estudio minucioso del hemograma y el frotis de sangre periférica que se encuentran al alcance de todos los profesionales de la salud, facilitan el rápido reconocimiento de cualquier rasgo anormal que permita orientar el proceso diagnóstico y terapéutico.

Valoraciones
No hay valoraciones aún.